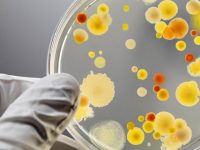
Fungos: Por que 75% das mulheres podem sofrer com infecções fúngicas?

Como curar torcicolo: Veja os melhores remédios e tratamentos caseiros
São raras as pessoas que nunca tiveram um torcicolo, essa condição que causa dor e dificuldade de movimentar o pescoço para um dos lados. O torcicolo é uma condição simples e que se resolve sozinho na maioria dos casos, no entanto, há situações que merecem mais atenção e tratamentos médicos. Hoje, vamos conhecer mais sobre […]